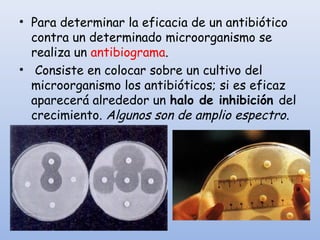
• Para determinar la eficacia de un antibiótico
contra un determinado microorganismo se
realiza un antibiograma.
• Consiste en colocar sobre un cultivo del
microorganismo los antibióticos; si es eficaz
aparecerá alrededor un halo de inhibición del
crecimiento. Algunos son de amplio espectro.

Este documento trata sobre salud y enfermedad. Define salud como un estado de bienestar físico, mental y social, no solo la ausencia de enfermedad. Explica que una enfermedad es cualquier alteración del funcionamiento del organismo. Describe los síntomas, tipos de enfermedades según su origen, duración y frecuencia. Además, explica las defensas del organismo contra las infecciones y cómo prevenir y tratar las enfermedades.